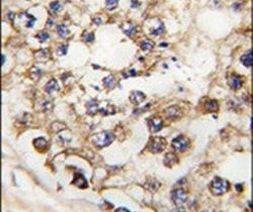
PDX1 Antibody in Immunohistochemistry (IHC)

Search
Invitrogen
PDX1 Polyclonal Antibody
{{$productOrderCtrl.translations['antibody.pdp.commerceCard.promotion.promotions']}}
{{$productOrderCtrl.translations['antibody.pdp.commerceCard.promotion.viewpromo']}}
{{$productOrderCtrl.translations['antibody.pdp.commerceCard.promotion.promocode']}}: {{promo.promoCode}} {{promo.promoTitle}} {{promo.promoDescription}}. {{$productOrderCtrl.translations['antibody.pdp.commerceCard.promotion.learnmore']}}
产品信息
PA5-14823
宿主/亚型
分类
类型
抗原
偶联物
形式
浓度
保存条件
运输条件
RRID
靶标信息
The protein encoded by this gene is a transcriptional activator of several genes, including insulin, somatostatin, glucokinase, islet amyloid polypeptide, and glucose transporter type 2. The encoded nuclear protein is involved in the early development of the pancreas and plays a major role in glucose-dependent regulation of insulin gene expression. Defects in this gene are a cause of pancreatic agenesis, which can lead to early-onset insulin-dependent diabetes mellitus (NIDDM), as well as maturity onset diabetes of the young type 4 (MODY4).
仅用于科研。不用于诊断过程。未经明确授权不得转售。